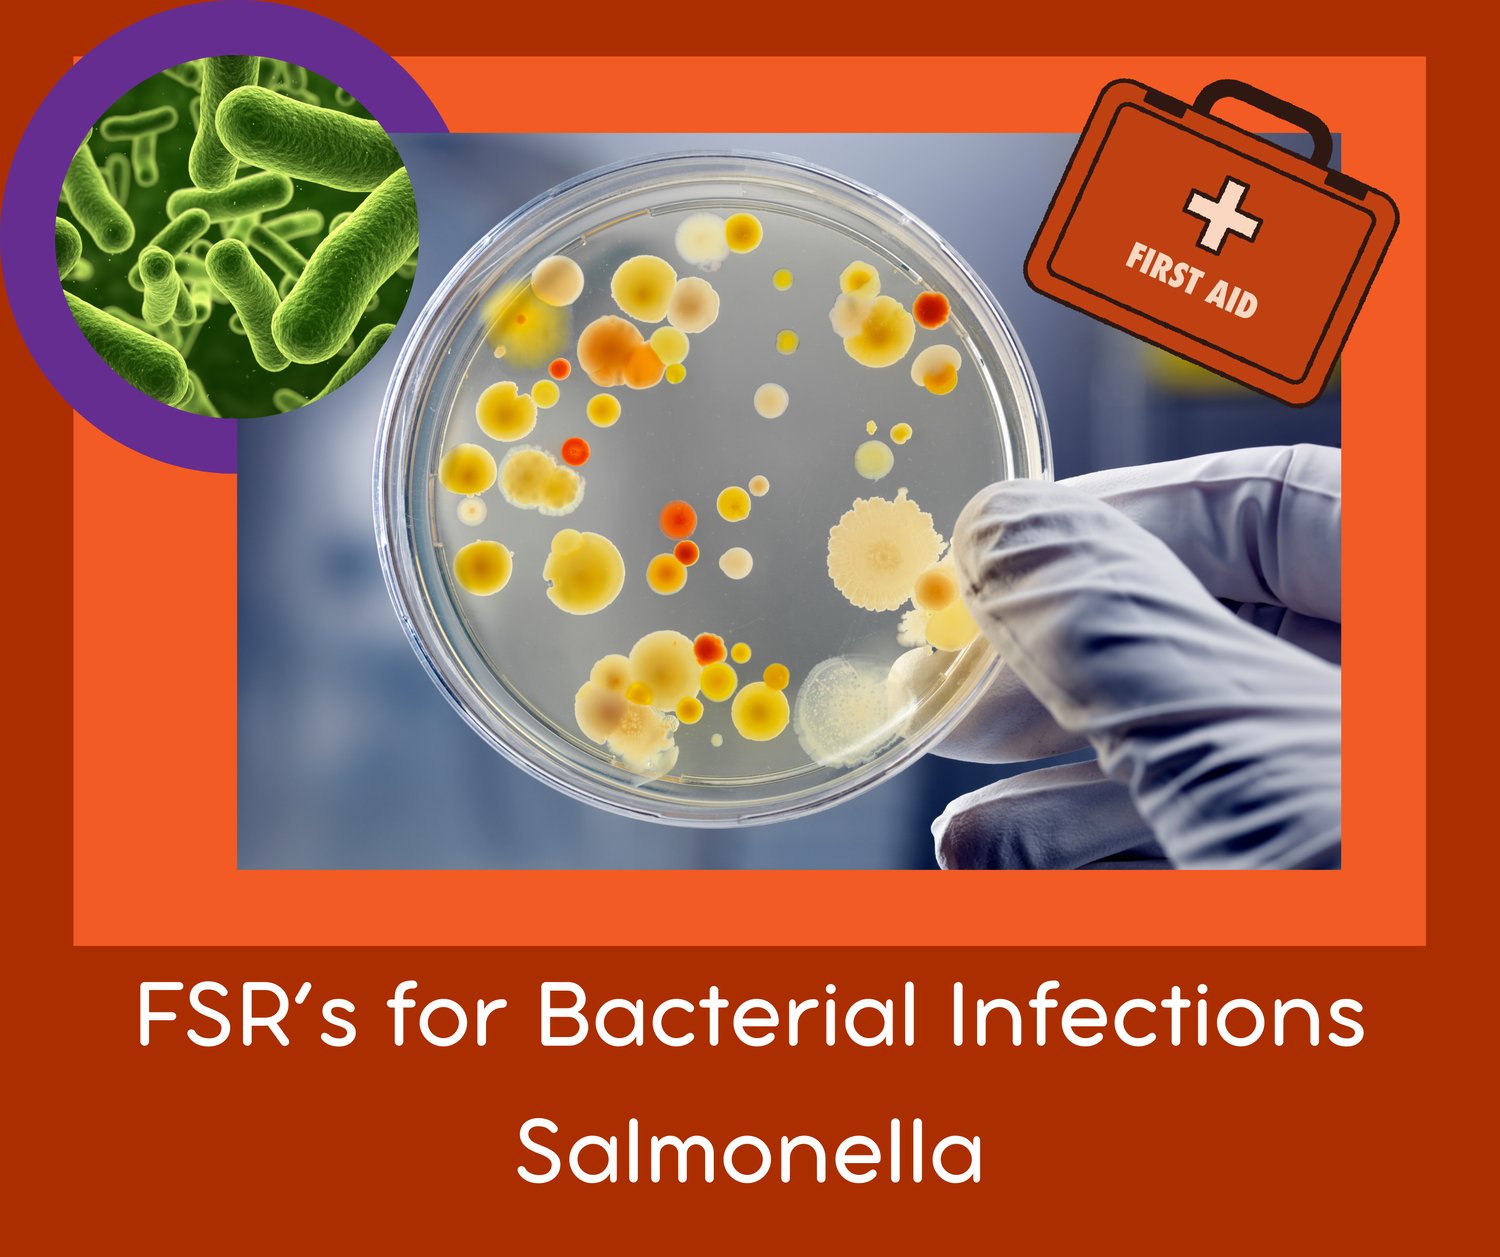

FSR Full First Aid set for Salmonella Bacterial Infections:- 9x FSR's
FSR's are sound files that, when played on your body, influence the vibration of your body. The result of this is that your system can have a positive change in response to the sound.
Our FSRs are constructed from modulated scalar waves, and are a combination of frequencies from around the world that have been proven to work over decades of trials in countries where such interventions are not frowned on. The frequencies we use have been adjusted to work with the Sony Headset - and as such play between 12 and 22000 Hz. This is a unique feature that makes it possible to effectively use a simple $20 delivery from an Android phone.
These are Salmonella Resonance Treatment files.
Remember to drink plenty of fluids and eat healthy foods (broths and soups, honey & lemon, citrus).
Use the FSRs in a playlist over your throat or infected area for at least 30 minutes twice a day. You can sleep with the set if you need to.
WASH YOUR HANDS!!! Wipe down surfaces with hydrogen peroxide (It is $1 at Walmart for a whole bottle. Get the $1 spray bottle too and use that for easy application.) Wash pillow cases and bedding often.
Adding immune support teas and increasing Vit C to gut tolerance may be very useful in building the immune system. The usual immune builders are all beneficial - garlic, Oregano, tea tree, Licorice, Vit D.
Burdock Root tea will help the inflammation and pain. If you can, eat the pieces of the root. They are chewy. I like them. Remember, for a tea to be medicine you need to take a 1/4 cup every 2 hours.
If the issue is bacterial in origin, these will still have some effect and the multiple benefits of garlic, oregano and tea tree will deal with bacteria as well.
If diagnosed correctly, playing this FSR over the affected area can stop the discomfort.
FSR's in this set:
- Salmonella Comp P-SMS 3 min.ogg (1.5 mb)
- Salmonella Enteriditis P-SMS 3 min.ogg (951 kb)
- Salmonella Infections H-SMS 3 min.ogg (1.9 mb)
- Salmonella Paratyphi #2 P-SMS 3 min.ogg (723 kb)
- Salmonella Paratyphi B P-SMS 3 min.ogg (1.2 mb)
- Salmonella P-SMS 3 min.ogg (1.1 mb)
- Salmonella Type B P-SMS 3 min.ogg (777 kb)
- Salmonella Typhi P-SMS 3 min.ogg (930 kb)
- Salmonella Typhimurium P-SMS 3 min.ogg (969 kb)